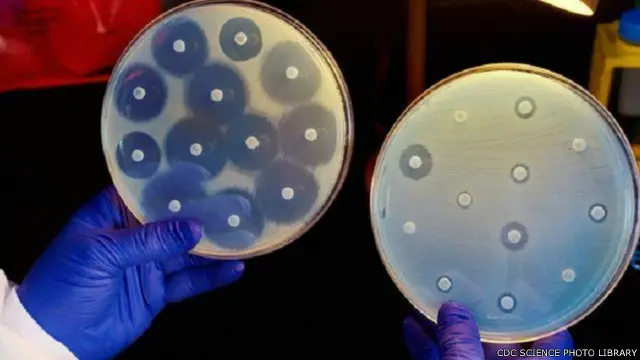

ما سر الأهمية القصوى للمضادات الحيوية؟

صدر الصورة، ALFRED PASIEKA SPL
- Author, فيرغاس ويلش
- Role, مراسل شؤون الصحة-بي بي سي
تحتاج إلى العودة للوراء 70 عاما لتعرف كيف كانت الإصابة بجرح أو عدوى شائعة سببا محتملا للوفاة.
كانت الجراحة العادية والولادة أمرا محفوفا بالمخاطر.
واكتشف البنسلين عام 1928 من قبل السير الكسندر فلمنغ، لكن التجارب على البشر لم تبدأ إلا بعد مرور أكثر من عقد من الزمان.
وكان أول مريض خذع لتجربة البنسلين، رجل شرطة من أوكسفورد يدعى البرت الكسندر، والذي أصيب بجرح في وجهه بسبب شوكة أحد الزهور، ثم تلوث الجرح جراء عدوى خطيرة.
وجرى علاج الكسندر بالبنسيلين وتحسنت حالته سريعا، لكن المخزون نفد قبل شفائه تماما، وتوفي بعد ذلك.
وبنهاية الحرب العالمية الثانية، جرى إنتاج كميات كبيرة من البنسيلين وأعقبته سريعا أدوية أخرى، وهو ما يمثل بداية حقبة المضادات الحيوية.
ولذلك فإن معظمنا نشأ في ظل توافر لهذه الأدوية التي تحقق المعجزات.
ومن المعروف أن المرضى وبعض الأطباء لا يمكنهم ببساطة استيعاب عالم ما قبل المضادات الحيوية لكن هذا الأمر يظل على المحك حتى يؤخذ التهديد على محمل الجد.
صدر الصورة، CDC SCIENCE PHOTO LIBRARY
انتشار الجراثيم
ويعتمد معظم الطب الحديث الآن على المضادات الحيوية حيث انتشرت الجراحة بشكل كبير أكثر من السابق، بداية من زراعة فخذ صناعي وعلاج السرطان وزرع الأعضاء فإن المضادات الحيوية ضرورية لمنع وعلاج العدوى.
وأطلقت دعوات متكررة للأطباء للتقليل من الاستخدام المفرط للمضادات الحيوية المستمر منذ سنوات عديدة.
أتذكر أنني كتبت مقالا يناقش تقريرا أصدرته لجنة في مجلس اللوردات عام 1998 ينتقد الأطباء الممارسين بسبب وصف مضادات حيوية لبعض المرضى الذين لايحتاجونها.
وشدد هذا التقرير على ضرورة تجنيب المرضى الاعتماد على المضادات الحيوية التي اعتادوا تناولها.
وبعد مرور نحو عقدين، أصدر المعهد الوطني للرعاية والتميز الصحي في بريطانيا المعروف اختصارا بـ"NICE" تقديرات تقول إن واحدة من كل أربع وصفات لتناول المضادات الحيوية غير ضرورية.
وبالرغم من أنه من المهم أن تمارس هيئة الخدمات الصحية البريطانية قيادة أفضل لتنظيم تناول المضادات الحيوية، فإنه من الجدير التذكير بأن هذه مشكلة عالمية تتطلب حلولا دولية.
أما حالات العدوى الجرثومية فلا تعرف حدودا وانتشرت من قارة إلى أخرى بسهولة.
وهناك قلق خاص لأن العديد من البلدان النامية لديها قيود أضعف بكثير من القيود المفترضة على استخدام المضادات الحيوية.
وفي حلقة برنامجي "بانوراما: المضادات الحيوية ونهاية العالم" والتي بثت في وقت سابق من هذا العام على بي بي سي ، ركزت على التحقيق في انتشار الجراثيم وسهولة شراء المضادات الحيوية دون أي استشارة طبية في الهند.
في العقد الماضي أصبحت الهند أكبر مستهلك للمضادات الحيوية في العالم، وانتشرت العدوى المقاومة للأدوية في العديد من المستشفيات.
لكن هذه ليست مشكلة في دول العالم النامي فقط.
سوء الاستخدام
توصلت منظمة الصحة العالمية العام الماضي إلى أن بعض المضادات الحيوية يمكن شرائها بشكل قانوني دون وصفة طبية في 19 من 43 دولة أوروبية خضعت للدراسة.
وهناك سوء استخدام للمضادات الحيوية على نطاق واسع في الزراعة في حيوانات المزارع والأسماك.

صدر الصورة، EYEWIRE.INC
وتستخدم المضادات الحيوية في الإنتاج الحيواني أكثر من الصحة البشرية، وهناك قلق واسع بشأن استخدام المضادات الحيوية بجرعات قليلة على المدى الطويل في الأعلاف الحيوانية في بلدان مثل الولايات المتحدة والصين والهند.
ويعود جزء من المشكلة إلى ضغط بسيط يتعلق بالتطور، فالبكتريا تتطور باستمرار وبدأت تظهر سلالات منها تقاوم العلاج.
وهذا يعني أن هناك صراع مستمر لاتخاذ خطوات مسبقة لمواجهة الجراثيم.
لكن تطوير مضادات جديدة أثبت أنه مهمة شاقة للغاية، إذ أنه مر تقريبا 30 عاما منذ طرح آخر فئة جديدة من المضادات الحيوية في السوق.
ويعد مرضى مثل غراهام غاتسون مثالا على مدى خطورة الإصابة بعدوى بجراثيم قوية.
قضى غاتسون خمسة أشهر هذا العام في أحد المستشفيات في ليفربول بعد أن أصيب بالعدوى بجراثيم قوية في الدم مقاومة للأدوية.
في بعض الفترات، كان يعاني من الهذيان لأن السموم البكتيرية أثرت على المخ.
لقد عاد الآن إلى منزله، لكنه لا يزال يتناول بعض المضادات الحيوية في محاولة للحيلولة دون عودة العدوى مرة أخرى.
أخبرني غاتسون أنه لم يكن ليبقى على قيد الحياة لولا المضادات الحيوية، وأنه مثل الكثير منا لم يدرك أهميتها قبل مرضه.
ويشرف خبير الاقتصاد جيم أونيل على دراسة لمضادات الميكروبات لا تبحث فقط في الأمراض البكتيرية، لكن أيضا العدوى الطفيلية والفيروسية مثل الملاريا وفيروس نقص المناعة البشرية المكتسب "اتش اي في" المسبب للأيدز.
ونشر اللورد أونيل بالفعل التوصيات الأولية لحل هذه الأزمة والتي تشمل توفير صندوق لتعزيز الأبحاث في هذا المجال، وسينشر التقرير النهائي لأونيل العام المقبل.








